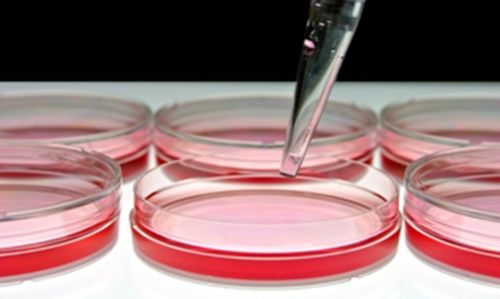

| Grant: | Establishing and developing competence centres, (2022-1.1.1-KK-2022-00005) |
| Amount of support: | 473.356.490 Ft |
| Duration: | 2023.04.01- 2027.03.31 |
| Principal investigator: | Anikó Görbe, MD, PhD |
The aim of the project is to develop a computer tool, the Combination Calculator, to help determine which drug combinations are most effective for cancer patients. It will be developed using laboratory cell lines to test the effects of the treatments suggested by the calculator. This will be done by molecular analysis and drug testing (e.g. cell viability, drug sensitivity). The goal is to lay the foundation for the future of personalised anticancer therapies by comparing computer predictions with experimental results.
The aim of the project is to produce mesenchymal stem cells for therapeutic use and to build the infrastructure and technology to support this. As part of this, a clean room laboratory (TTL) will be designed and built to enable the production of human umbilical cord-derived stem cells. In parallel, Semmelweis University experts will develop the manufacturing processes in an existing laboratory to ensure a smooth transfer. The project will also include detailed studies on the properties of the cells and their extracellular vesicles. Once the manufacturing technology has been transferred, pre-clinical trials will begin, followed by the first clinical trials if the results are successful. The long-term goal of the research is to develop stem cell-based therapies that effectively support the immune system and have regenerative and cardioprotective effects.
Participating leading researchers, collaboration partners, universities, companies
The project is led Anikó Görbe, Associate Professor and Deputy Director of the Institute of Pharmacology and Pharmacotherapy at Semmelweis University. We are collaborating with the teams led by László Cenevák at the Department of Internal Medicine and Haematology and Krisztián Németh at the Department of Dermatology, Nematology and Dermatroncology of Semmelweis University. Within the consortium, we are collaborating with Genomate Health Kft, a leading Hungarian biotechnology company developing precision oncology solutions to support personalised anticancer therapies, and Richter Gedeon Nyrt, one of Hungary’s largest pharmaceutical companies, which is active internationally in the field of innovative drug development.
Applied methods and tools
The project will use state-of-the-art laboratory and biotechnological methods, including stem cell isolation, cell viability and cytotoxicity assays (e.g. IC50, AUC) and molecular characterisation. For cell analysis we use flow cytometry, ELISA assays and in vitro and in vivo model systems. In addition, isolation and characterisation of extracellular vesicles and omics-based molecular assays (e.g. microarray) are performed. The project will also include the construction of a clean room laboratory for development and the provision of a GMP-compliant manufacturing environment.
Pictures
Mission and benefits
Our research aims to develop new personalised cellular and drug therapies for the treatment of cancer and regenerative diseases. We will build state-of-the-art laboratory infrastructure and use innovative methods to test stem cells and drug combinations. This work will strengthen Semmelweis University’s research excellence, support patient-centred innovation and contribute to international collaborations, while also providing training opportunities.